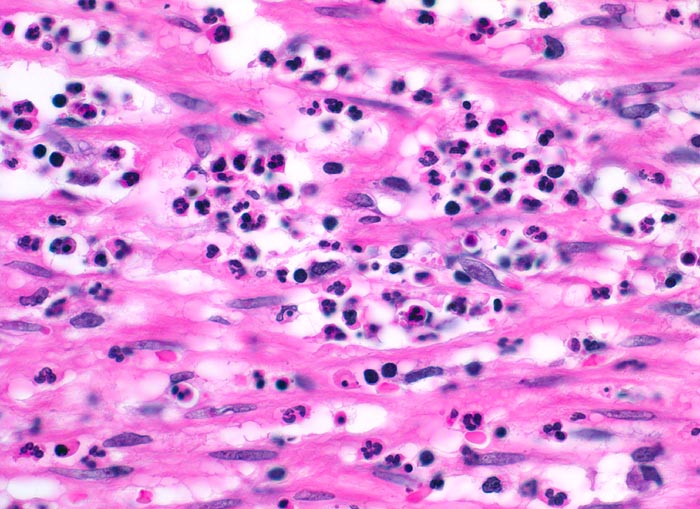

PathoPic – image database / PathoPic ID 3432 - akute Appendizitis: phlegmonöse Entzündung
de
Diagnose
akute Appendizitis: phlegmonöse Entzündung
Diagnose Gruppe
Entzündung / Reparatur
Topographie
Appendix vermiformis
Topographie Gruppe
Darm, Anus
Beschreibung
Die glatte Muskulatur der Appendixwand wird diffus infiltriert von neutrophilen Granulozyten.
Zusatzbefund
-
Klinik
Seit 6 Stunden Schmerzen im Unterbauch rechts mit zunehmender lokaler Druckempfindlichkeit. Übelkeit.
Bilder Typ
Histologie
Vergrösserung
400
Alter
8
Geschlecht
männlich
Datum
Ersteintrag: 17.12.2001